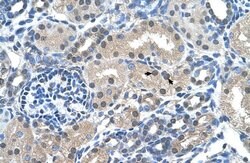
Invitrogen FKBP6 Polyclonal Antibody 100 &mu;L; Unconjugated:Antibodies,

missing translation for 'onlineSavingsMsg'
Learn More
Learn More
Invitrogen™ FKBP6 Polyclonal Antibody


Rabbit Polyclonal Antibody
Brand: Invitrogen™ PA542282
This item is not returnable.
View return policy
Description
Peptide sequence: FCALSAEQQD QFPLQKVLKV AATEREFGNY LFRQNRFYDA KVRYKRALLL Sequence homology: Cow: 100%; Dog: 100%; Guinea Pig: 77%; Horse: 100%; Human: 100%; Mouse: 100%; Pig: 100%; Rabbit: 100%; Rat: 100%.
FKBP6 is a member of the immunophilin protein family, which play a role in immunoregulation and basic cellular processes involving protein folding and trafficking. FKBP6 is a cis-trans prolyl isomerase that binds to the immunosuppressants FK506 and rapamycin.This gene encodes a member of the interferon regulatory transcription factor (IRF) family. Family members share a highly-conserved N-terminal helix-turn-helix DNA-binding domain and a less conserved C-terminal protein-binding domain. Mutations in this gene can cause van der Woude syndrome and popliteal pterygium syndrome. This protein is involved in palate formation.
Specifications
| FKBP6 | |
| Polyclonal | |
| Unconjugated | |
| Fkbp6 | |
| 1700008G22Rik; 36 kDa FK506 binding protein; 36 kDa FK506-binding protein; 36 kDa FKBP; 36kDa; As; AU017274; D5Ertd724e; FK506 binding protein 6; FK506 binding protein 6, 36kDa; FK506-binding protein 6; FK506-binding protein 6 (36kD); FKBP prolyl isomerase 6; FKBP prolyl isomerase family member 6 (inactive); Fkbp36; FKBP-36; FKBP6; FKBP-6; Immunophilin FKBP36; Inactive peptidyl-prolyl cis-trans isomerase FKBP6; Inactive PPIase FKBP6; MGC87179; peptidyl-prolyl cis-trans isomerase FKBP6; PPiase; PPIase FKBP6; rotamase | |
| Rabbit | |
| Protein A | |
| RUO | |
| 8468 | |
| -20°C, Avoid Freeze/Thaw Cycles | |
| Liquid |
| Immunohistochemistry, Western Blot | |
| 1 mg/mL | |
| PBS with 2% sucrose and 0.09% sodium azide | |
| O75344 | |
| Fkbp6 | |
| Synthetic peptide directed towards the middle region of human FKBP6. | |
| 100 μL | |
| Primary | |
| Human | |
| Antibody | |
| IgG |
Product Content Correction
Your input is important to us. Please complete this form to provide feedback related to the content on this product.
Product Title
Spot an opportunity for improvement?Share a Content Correction